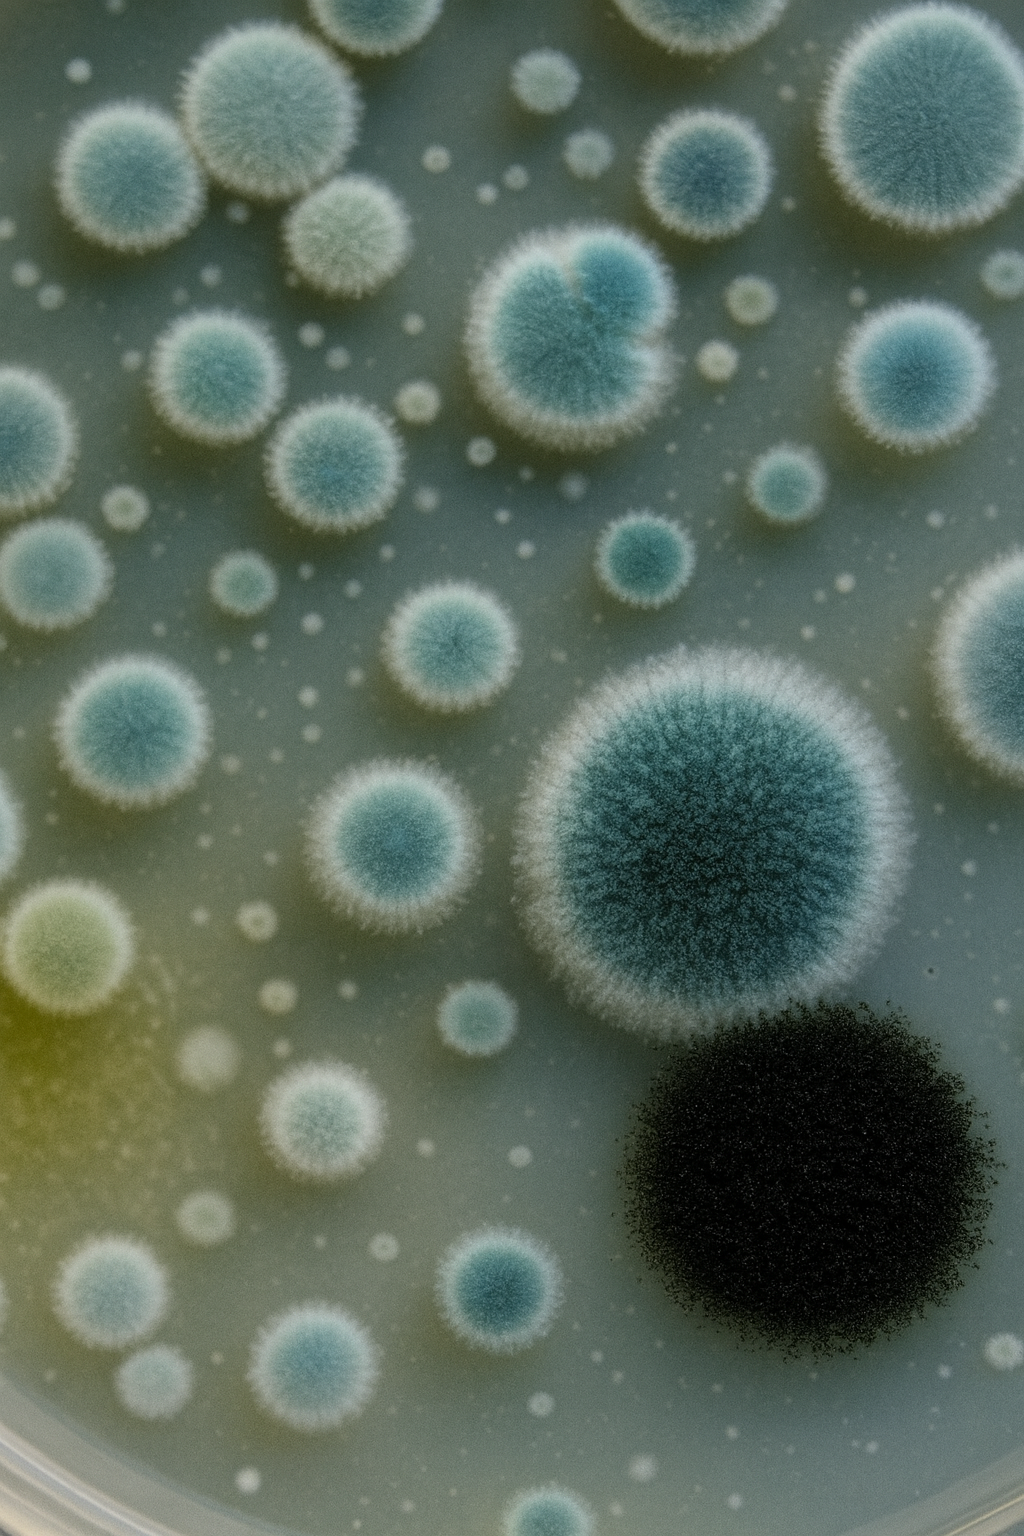
Почему появляется плесень?

Мы на протяжении 30 лет совершенствуем тактику борьбы с плесенью. Коротко познакомим с нашей методикой:
Плесень — это частая проблема во многих домах и квартирах. Основными причинами её появления являются высокая влажность и недостаточная вентиляция. Влага скапливается на стенах, в углах комнат, в ванных и подвалах, создавая идеальные условия для роста плесени.
Для эффективного уничтожения плесени в квартире важно выявить источник проблемы и устранить его. Профессиональное удаление плесени включает в себя использование специализированных средств и методов, которые помогают полностью избавиться от плесени на стенах, мебели и обоях. Особенно важно уделить внимание зонам с высокой влажностью, таким как ванные комнаты и подвалы.
Уничтожение плесени в ванной комнате и на кухне требует регулярной чистки и поддержания оптимального уровня влажности. Также не следует забывать про обработку углов и стыков, где плесень часто начинает развиваться. В новостройках и офисах плесень может появиться из-за недостаточной просушки строительных материалов, поэтому профессиональное уничтожение грибка там особенно актуально.
Если плесень поразила потолок или мебель, необходимо незамедлительно заняться её удалением, чтобы предотвратить дальнейшее распространение. Борьба с плесенью в жилых помещениях требует комплексного подхода, включающего как механическое удаление, так и профилактические меры.
Таким образом, уничтожение грибка и плесени в доме — это важный процесс, который требует как специальных знаний, так и профессиональных средств для удаления плесени
Подготовим всю необходимую документацию для отчета для Роспотребнадзора и Россельхознадзора
Оказываем услуги юридическим лицам. Индивидуальный договор и полный пакет документов на работы и средства
Пакет документов, о проделанных работах, уже входит в стоимость
Бесплатная консультация Врача-Дезинфектолога – разработка индивидуальных мер, а также рекомендаций по предотвращению появления грызунов
Бережно относимся к вашему времени, помещению и оборудованию
Уничтожение плесени в квартире — важный процесс для поддержания здоровья и уюта. Плесень на стенах, в углах или на обоях не только портит внешний вид помещения, но и может вызывать заболевания. Для эффективного удаления плесени в ванной, подвале или санузле важно использовать профессиональные средства для удаления плесени. Профессиональное уничтожение грибка и плесени гарантирует качественный результат. Важно также принять меры по предотвращению повторного появления плесени в доме. Если вам необходимо уничтожение плесени в частном доме или новостройке, обратитесь к нам для гарантированного решения проблемы.

По совету решили заключить договор именно с этой фирмой — «Санитария и Гигиена» - хотя конкуренция на этом рынке высокая. Чуть позже стало ясно почему именно ее стоит выбирать. Всё делается этими ребятами быстро и по регламенту, четко под надзором государственных органов. В начале заводят папку со всеми документами и сертификатами, обновляют данные в этой папке самостоятельно, предоставляют полный перечень необходимой документации, которые при всех проверках и во всех инстанциях будут преимуществом. Что крайне немаловажно, качество дезинф. услуг, нареканий у нас не было, строго по списку и уложились в достаточно сжатые сроки. Так что можно к ним обращаться и по факту заданий, и по требованиям бюрократии. Сочетание полезности-контроля-бумажной волокиты тут самое оптимальное, из того, с чем приходилось сталкиваться. Таким образом — рекомендуем к сотрудничеству.
Выражаем благодарность 000 «САНИТАРИЯ и ГИГИЕНА» за безупречное выполнение по Договору N- 01/08/17-Д от 01.08.2017r в части истребительской и профилактической дератизации и дезинсекции с целью предупреждения возникновения и распространения инфекционных заболеваний на территории предприятия ООО «АГРОПРОДУКТ›.
ООО «Группа «Атлантис» информирует, ООО «Санитария и гигиена» осуществляет стабильное и качественное сотрудничество при проведении дератизации и дезинсекции предприятия и прилегающих территорий. Все проводится качественно, ответственно и в срок. На все дополнительные заявки сотрудники откликаются быстро. Всегда имеется обратная связь от руководства и персонала фирмы. Дезинсекция проводится в удобное для предприятия время (выходной, праздничный день, любое время суток: день/ночь). Учитываются все пожелания по предоставлению и ведению необходимой документации, с целью интеграции в систему менеджмента качества предприятия и требований стандартов, по которым сертифицировано предприятие. Персонал имеет соответствующее обучение, которое помогает при возникновении и решении вопросов.
Фирма ООО «САНИТАРИЯ И ГИГИЕНА» более 2 лет является нашим партнером и помощником в поддержании соответствия производства требованиям санитарной безопасности.
За время сотрудничества ООО «САНИТАРИЯ И ГИГИЕНА» проявили себя как ответственная, нацеленная на результат, лояльная, гибкая команда профессионалов, способная предоставить дезинфекцию качественно и в установленный срок.
Сервис включает своевременное выполнение и полное документальное оформление обязательного комплекса дезинфекционных мероприятий и мониторинга, предписанных требованиями санитарного законодательства РФ и требованиями системы менеджмента безопасности пищевой продукции в соответствии с ГОСТ Р ИСО 22000. Рекомендации специалистов по итогам мониторинга позволяют вовремя предотвратить возможные риски и быть уверенными в безопасности условий производственной площадки.
Благодарственное письмо
Уважаемые партнеры, хотим выразить свое благодарность за добросовестное и качественное оказание сервиса по дератизации и дезинсекции. Ваша фирма имеет высококвалифицированный и доброжелательный персонал, который ответственно относится к выполнению дезинсекции . За все время не возникло ни одной задачи, которую бы не смогли решить ваши специалисты.
Очень рады, что на рынке дератизации и дезинсекции есть такие профессионалы, которые постоянно работают над улучшением качества .
Уважаемые коллеги, настоятельно рекомендуем по вопросам, связанными с дератизацией и дезинфекцией, обращаться в ООО «Санитария и Гигиена».
Специалисты компании профессионалы своего дела. Работу выполнили качественно, приезжали всегда вовремя и нашли индивидуальный подход к нашей организации, что подчеркивает высокий уровень их компетенции. Были очень рады сотрудничеству.
Наш ресторан очень серьезно относится к вопросу дезинфекции помещения и благодаря вашей компании все прошло отлично. Мы заметили заметное улучшение чистоте и пищевой безопасности. Большое спасибо за оперативность и качественную работу
Благодаря вашей компании по дезинфекции помещения, наша кондитерская стала еще более безопасным для наших гостей и сотрудников. Все было сделано качественно и в срок. Спасибо за профессионализм и ответственный подход!